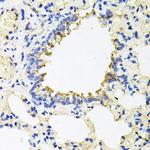
CALU Antibody in Immunohistochemistry (Paraffin) (IHC (P))

Search
Invitrogen
CALU Polyclonal Antibody
{{$productOrderCtrl.translations['antibody.pdp.commerceCard.promotion.promotions']}}
{{$productOrderCtrl.translations['antibody.pdp.commerceCard.promotion.viewpromo']}}
{{$productOrderCtrl.translations['antibody.pdp.commerceCard.promotion.promocode']}}: {{promo.promoCode}} {{promo.promoTitle}} {{promo.promoDescription}}. {{$productOrderCtrl.translations['antibody.pdp.commerceCard.promotion.learnmore']}}

Please note: We are reviewing Western blot images included in the antibody testing data in our catalog, including those provided by third parties. Unless expressly labeled or annotated as “raw-unedited”, Western blot images included in the antibody testing data in our catalog may have been edited, optimized or otherwise adjusted for presentation.
产品信息
PA5-109479
种属反应
宿主/亚型
分类
类型
抗原
偶联物
形式
浓度
规格
纯化类型
保存液
内含物
保存条件
运输条件
RRID
产品详细信息
Immunogen sequence: KPTEKKDRVH HEPQLSDKVH NDAQSFDYDH DAFLGAEEAK TFDQLTPEES KERLGKIVSK IDGDKDGFVT VDELKDWIKF AQKRWIYEDV ERQWKGHDLN EDGLVSWEEY KNATYGYVLD DPDPDDGFNY KQMMVRDERR FKMADKDGDL IATKEEFTAF LHPEEYDYMK DIVVQETMED IDKNADGFID LEEYIGDMYS HDGNTDEPEW VKTEREQFVE FRDKNRDGKM DKEETKDWIL PSDYDHAEAE ARHLVYESDQ NKDGKLTKEE IVDKYDLFVG SQATDFGEAL VRHDEF
靶标信息
Caluminin is a 315 amino acid Ca2+-binding member of the CREC, EF-hand protein family. Calumenin is a secreted protein t hat contains six Ca2+-binding (EF-hand) motifs and is expressed in the lumen of the endoplasmic reticulum (ER) and Golgi apparatus. In the presence of Ca2+, Calumenin interacts with serum amyloid P component (SAP) and, together, they may play a role in the immunological defense system and participate in amyloidosis, the pathological formation of amyloid deposits in different types of tissues. Calumenin has an inhibitory effect on the vitamin K-dependent g-carboxylation system which converts vitamin K-dependent proteins to Gla-containing proteins. Calumenin may also be involved in the pathophysiology of thrombosis and/or wound healing by acting in an autocrine or paracrine manner.
仅用于科研。不用于诊断过程。未经明确授权不得转售。
篇参考文献 (0)
生物信息学
蛋白别名: Calumenin; CBP-50; Crocalbin; IEF SSP 9302; reticulocalbin
基因别名: 9530075H20Rik; CALU; Cbp50; Rcn
UniProt ID: (Mouse) O35887
Entrez Gene ID: (Mouse) 12321, (Rat) 64366




